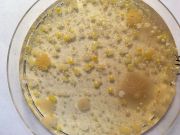
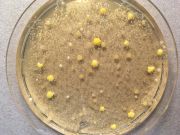
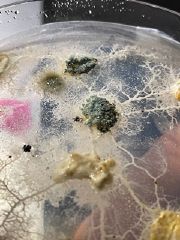

This special page shows all uploaded files.
| Date | Name | Thumbnail | Size | Description | Versions |
|---|---|---|---|---|---|
| 18:26, 9 June 2022 | WhatsApp Image 2022-06-09 at 8.22.18 PM.jpeg (file) |  |
901 KB | File uploaded with MsUpload | 1 |
| 18:26, 9 June 2022 | WhatsApp Image 2022-06-09 at 8.20.51 PM.jpeg (file) |  |
307 KB | File uploaded with MsUpload | 1 |
| 18:26, 9 June 2022 | WhatsApp Image 2022-06-09 at 8.21.50 PM.jpeg (file) |  |
266 KB | File uploaded with MsUpload | 1 |
| 20:14, 12 May 2022 | Multiple-cameras-capture.maxpat (file) | 4 KB | File uploaded with MsUpload | 1 | |
| 20:11, 12 May 2022 | EOSWebcamUtility-MAC1.0.pkg.zip (file) | 4.38 MB | File uploaded with MsUpload | 1 | |
| 13:57, 3 May 2022 | 11 Blob Tracking 4 blob-tracking.maxpat (file) | 252 KB | File uploaded with MsUpload | 1 | |
| 13:57, 3 May 2022 | 11 Blob Tracking 4 blob-tracking-euglena.maxpat (file) | 256 KB | File uploaded with MsUpload | 1 | |
| 09:40, 14 April 2022 | Inhalt bioelectronics final greenpages o.pdf (file) | 13.07 MB | File uploaded with MsUpload | 1 | |
| 06:37, 14 April 2022 | 5-galvanic-sensor-basic.png (file) |  |
7.09 MB | File uploaded with MsUpload | 1 |
| 06:33, 14 April 2022 | 4-PhotoCellA0.png (file) |  |
183 KB | File uploaded with MsUpload | 1 |
| 06:33, 14 April 2022 | 3-direct-current-electricity.png (file) |  |
717 KB | File uploaded with MsUpload | 1 |
| 06:33, 14 April 2022 | 2-free-electrons.png (file) |  |
165 KB | File uploaded with MsUpload | 1 |
| 06:33, 14 April 2022 | 1-atom.png (file) |  |
164 KB | File uploaded with MsUpload | 1 |
| 15:26, 9 April 2022 | MIMG 0010 2.JPG (file) |  |
1.39 MB | File uploaded with MsUpload | 1 |
| 15:26, 9 April 2022 | MIMG 0010 1.JPG (file) |  |
1.39 MB | File uploaded with MsUpload | 1 |
| 10:32, 4 February 2022 | Nik Header.png (file) |  |
1.98 MB | File uploaded with MsUpload | 1 |
| 17:06, 15 December 2021 | C-page6.png (file) |  |
56 KB | File uploaded with MsUpload | 1 |
| 17:06, 15 December 2021 | C-page5.png (file) |  |
31 KB | File uploaded with MsUpload | 1 |
| 17:06, 15 December 2021 | C-page4.png (file) |  |
47 KB | File uploaded with MsUpload | 1 |
| 17:06, 15 December 2021 | C-page3.png (file) |  |
320 KB | File uploaded with MsUpload | 1 |
| 17:06, 15 December 2021 | C-page2.png (file) |  |
56 KB | File uploaded with MsUpload | 1 |
| 17:06, 15 December 2021 | C-page1.png (file) |  |
356 KB | File uploaded with MsUpload | 1 |
| 11:39, 27 November 2021 | Bacteria exchange.pdf (file) | 48 KB | File uploaded with MsUpload | 1 | |
| 11:09, 27 November 2021 | P-IMG00186.jpg (file) |  |
425 KB | File uploaded with MsUpload | 1 |
| 11:09, 27 November 2021 | P-IMG00169.jpg (file) |  |
346 KB | File uploaded with MsUpload | 1 |
| 11:09, 27 November 2021 | P-IMG00163.jpg (file) |  |
417 KB | File uploaded with MsUpload | 1 |
| 11:09, 27 November 2021 | P-IMG00146.jpg (file) |  |
318 KB | File uploaded with MsUpload | 1 |
| 11:09, 27 November 2021 | P-IMG00083.jpg (file) |  |
448 KB | File uploaded with MsUpload | 1 |
| 11:09, 27 November 2021 | P-IMG00064.jpg (file) |  |
507 KB | File uploaded with MsUpload | 1 |
| 11:09, 27 November 2021 | P-IMG00060.jpg (file) |  |
548 KB | File uploaded with MsUpload | 1 |
| 11:09, 27 November 2021 | P-IMG00018.jpg (file) |  |
514 KB | File uploaded with MsUpload | 1 |
| 11:09, 27 November 2021 | P-IMG00014.jpg (file) |  |
636 KB | File uploaded with MsUpload | 1 |
| 09:58, 27 November 2021 | 10-35-34 211127-103534-1916f.jpg (file) |  |
68 KB | File uploaded with MsUpload | 1 |
| 15:44, 25 November 2021 | P-image-005.jpg (file) |  |
1.48 MB | File uploaded with MsUpload | 1 |
| 15:41, 25 November 2021 | P-image-004.jpg (file) | |
1.78 MB | File uploaded with MsUpload | 1 |
| 15:41, 25 November 2021 | P-image-003.jpg (file) |  |
2.15 MB | File uploaded with MsUpload | 1 |
| 15:41, 25 November 2021 | P-image-002.jpg (file) | |
2.33 MB | File uploaded with MsUpload | 1 |
| 15:40, 25 November 2021 | P-image-001.jpg (file) |  |
1.48 MB | File uploaded with MsUpload | 1 |
| 15:40, 25 November 2021 | P-image-000.jpg (file) |  |
1.58 MB | File uploaded with MsUpload | 1 |
| 20:09, 14 November 2021 | Nicoloas image0.jpeg (file) |  |
2.61 MB | File uploaded with MsUpload | 1 |
| 19:00, 14 November 2021 | N IMG 3961.jpeg (file) |  |
54 KB | File uploaded with MsUpload | 1 |
| 19:00, 14 November 2021 | N IMG 3955.jpeg (file) | |
51 KB | File uploaded with MsUpload | 1 |
| 19:00, 14 November 2021 | N IMG 3528.jpeg (file) |  |
30 KB | File uploaded with MsUpload | 1 |
| 12:51, 14 November 2021 | Image-009.jpg (file) |  |
12 KB | File uploaded with MsUpload | 1 |
| 12:51, 14 November 2021 | Image-008.jpg (file) |  |
21 KB | File uploaded with MsUpload | 1 |
| 12:51, 14 November 2021 | Image-007.jpg (file) |  |
13 KB | File uploaded with MsUpload | 1 |
| 12:51, 14 November 2021 | Image-006.jpg (file) |  |
23 KB | File uploaded with MsUpload | 1 |
| 12:48, 14 November 2021 | Image-005.jpg (file) |  |
48 KB | File uploaded with MsUpload | 1 |
| 12:48, 14 November 2021 | Image-004.jpg (file) |  |
42 KB | File uploaded with MsUpload | 1 |
| 12:48, 14 November 2021 | Image-003.jpg (file) |  |
66 KB | File uploaded with MsUpload | 1 |